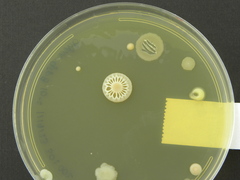
Actinomycetales

Actinomycetales: taxon details and analytics
- Domain
- Kingdom
- Bacteria
- Phylum
- Actinobacteria
- Class
- Order
- Actinomycetales
- Family
- Genus
- Species
- Scientific Name
- Actinomycetales
Summary description from Wikipedia:
Actinomycetales
The Actinomycetales is an order of Actinomycetota. A member of the order is often called an actinomycete. Actinomycetales are generally gram-positive and anaerobic and have mycelia in a filamentous and branching growth pattern. Some actinomycetes can form rod- or coccoid-shaped forms, while others can form spores on aerial hyphae. Actinomycetales bacteria can be infected by bacteriophages, which are called actinophages. Actinomycetales can range from harmless bacteria to pathogens with resistance to antibiotics.
...Actinomycetales in languages:
- Chinese
- 放線菌目
- Hungarian
- sugárgombák
- Thai
- อันดับ แบคทีเรียในปมรากสนทะเล แบคทีเรียก่อสิว และอื่น ๆ
Images from inaturalist.org observations:
We recommend you sign up for this excellent, free service.
Sibling Taxa
Child Taxa
- Actinomycetaceae
- Beutenbergiaceae
- Brevibacteriaceae
- Corynebacteriaceae
- Cryptosporangiaceae
- Dermacoccaceae
- Dermatophilaceae
- Frankiaceae
- Geodermatophilaceae
- Intrasporangiaceae
- Jiangellaceae
- Kineosporiaceae
- Microbacteriaceae
- Micrococcaceae
- Micromonosporaceae
- Mycobacteriaceae
- Nocardiaceae
- Nocardioidaceae
- Nocardiopsaceae
- Propionibacteriaceae
- Pseudonocardiaceae
- Sanguibacteraceae
- Sporichthyaceae
- Streptomycetaceae
- Streptosporangiaceae
- Thermomonosporaceae